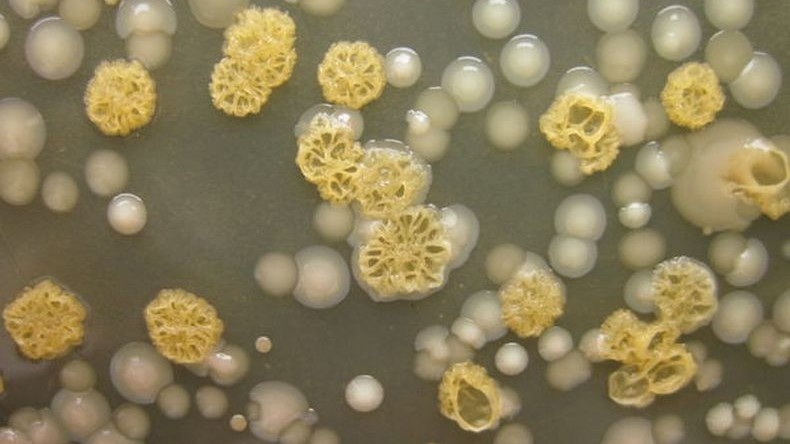
Mêmes les cellules des champignons sont xénophobes !

Mêmes les cellules des champignons sont xénophobes !
© Capture d'écran du compte de Twitter
© Capture d'écran du compte de Twitter Les scientifiques de l’Université de Californie à Berkeley ont découvert que les cellules d’un champignon microscopique, le Neurospora crassa, ne développent des colonies qu’avec celles qui leur ressemblent.
Le journal PLOS Biology a découvert que ces cellules de champignons font le choix de ne s’assembler qu’entre elles à cause du rôle joué par les gènes responsables des communications chimiques qu’elles peuvent établir. Sur la base de ce critère, ces cellules ne coopèrent qu’au sein des colonies qui possèdent la même «langue». Mais les scientifiques précisent que ces communications ne s’assimilent pas à celles que des personnes pourraient nouer entre elles mais reconnaissent qu’il existe différents «dialectes».
Le #robot raciste et xénophobe de #Microsoft est de retour… et avoue avoir fumé de la weed https://t.co/KmrNDtJta8pic.twitter.com/D3HVk0pErI
— RT France (@RTenfrancais) 30 mars 2016
C’est toutefois l’une des premières enquêtes qui montre la xénophobie des protozoaires. Par le passé, le site Gawker avait interrogé des spécialistes du comportement canin et avait déduit, à partir de leurs déclarations, que les chiens montraient souvent un comportement xénophobe. Certains animaux réagiraient systématiquement de manière agressive à l’approche d’une personne dont le couleur du peau diffère de celle de leur propriétaire.

















